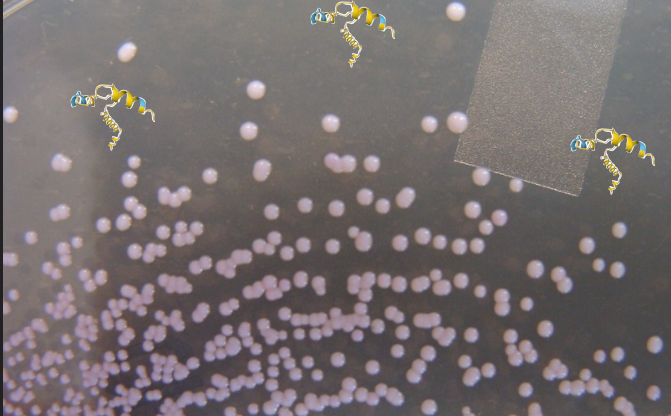

La-la-lantibiotiki
Raziskovalna skupina s Portugalske in Nemčije je v članku, objavljenem v reviji Colloid and Surfaces B: Biointerfaces, opisala mehanizem delovanja lantibiótika lichenicidína.
Z lantibiótiki označujemo protimikrobne peptide, ki jih izločajo bakterije. Za razliko od antibiotikov, ki učinkujejo proti širokemu spektru bakterij, gre v primeru lantibiótikov za bakteriocíne, kar pomeni, da učinkujejo proti ozkemu spektru bakterij, natančneje proti sorodnim vrstam ali celo zgolj drugim sévom iste bakterijske vrste.
Lantibiótiki kot protimikrobni peptidi praviloma sestojijo iz enega bifunkcionalnega encima ali pa iz dveh encimov, ki morata za protimikrobno učinkovanje delovati usklajeno. Njihova tarča je celična membrana bakterijske celice, na katero delujejo dvojno. Po eni strani se vežejo na določene molekule celične membrane, ki so ključne za izgradnjo celične stene. Ker jih z vezavo osamijo, na ta način preprečijo izgradnjo celične stene. Po drugi strani pa encimi v fluidni membrani povzročijo nastanek stabilnih por, kar vodi do poškodb, ki rezultirajo v izlitju celične notranjosti in s tem propadu celice.
Za namene prihodnje aplikativne uporabe lantibiótikov je nujno poznavanje natančnejšega delovanja posameznega antimikrobnega encima. Raziskovalna skupina je tako preučila delovanje lantibiotika lichenicidína. Najprej so protimikrobne peptide nagojili v bakteriji E.cóli, supernatant so centrifugirali, očistili in končno liofilizírali. Nato so učinek različnih koncentracij lantibiótika preverili na bakteriji Stafilokókus áureus in tudi na modelu lipidnih veziklov, ki posnemajo delovanje celične membrane. Ker je lichenicidín sestavljen iz dveh encimov, so poleg koncentracije spremljali tudi razlike v učinku, če je dodan zgolj posamičen encim ali pa če je njuno zaporedje obrnjeno.
Raziskovalke in raziskovalci so protimikrobni učinek lichenicidína najprej preverili na modelu lipidnih veziklov, ki so jih predhodno obdelali s fluorescenčnim barvilom. To jim je omogočilo, da so njihovo puščanje, ki je bilo posledica protimikrobnega delovanja encimov, merili z metodo fluorescenčne spektroskopije. Poskusi so pokazali, da se prvi encim ni dobro vezal na membrano vezikla in posamično tudi pri velikih koncentracijah ni prišlo do večjega iztekanja vsebine. Nasprotno je bil pri drugem encimu protimikrobni učinek precej bolj opazen, predvsem če je bil ta dodan v večjih koncentracijah. V primeru ko sta bila dodana oba encima ne glede na vrstni red, pa je do izraza prišla moč njunega skupnega učinkovanja, saj je do preluknjanja veziklov prišlo v več kot 90 odstotkih primerov.
Nastanek poškodb na bakterijskih celicah so potrdili tudi mikroskopski posnetki. Deformacije na površini celice so bile opazne že po eni uri inkubacije. V roku 24 ur pa je prišlo do izlitja in propada celice. Glede na opazovanja je raziskovalna skupina predlagala, da je za učinek lichenicidína ključen predvsem drugi encim, ki v celični membrani ustvari pore. Vendar prisotnost prvega encima močno poveča njegovo vezavo in stabilizacijo na membrani, kar pripomore k večji stabilnosti por in torej boljšemu protimikrobnemu učinku.
Pojavnost odpornosti mikroorganizmov proti antibiotikom je v porastu in že predstavlja težave za javno zdravje. Poznavanje delovanja lantibiótikov in njihova uporaba nam tako lahko v prihodnosti prideta še zelo prav.
Lantibiotike bo še naprej spremljala Teja.

Dodaj komentar
Komentiraj